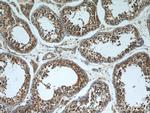
VDAC3 Antibody in Immunohistochemistry (Paraffin) (IHC (P))

Search
Proteintech
VDAC3 Polyclonal Antibody
{{$productOrderCtrl.translations['antibody.pdp.commerceCard.promotion.promotions']}}
{{$productOrderCtrl.translations['antibody.pdp.commerceCard.promotion.viewpromo']}}
{{$productOrderCtrl.translations['antibody.pdp.commerceCard.promotion.promocode']}}: {{promo.promoCode}} {{promo.promoTitle}} {{promo.promoDescription}}. {{$productOrderCtrl.translations['antibody.pdp.commerceCard.promotion.learnmore']}}
产品信息
55260-1-AP
种属反应
宿主/亚型
分类
类型
抗原
偶联物
形式
浓度
规格
纯化类型
保存液
内含物
保存条件
运输条件
产品详细信息
This antibody is specific to VDAC3.
靶标信息
The Voltage-Dependent Anion Channel (VDAC) of the outer mitochondrial membrane, a small abundant protein found in all eukaryotic kingdoms, forms a voltage-gated pore when incorporated into planar lipid bilayers. VDAC is also the site of binding of the metabolic enzymes hexokinase and glycerol kinase to the mitochondrion in what may be a significant metabolic regulatory interaction. VDAC3 is involved specifically in translocation of adenine nucleotides through the outer membrane.
仅用于科研。不用于诊断过程。未经明确授权不得转售。
生物信息学
蛋白别名: channel protein VDAC3; mitochondrial outer membrane protein; mitochondrial voltage dependent anion channel 3; mVDAC3; Non-selective voltage-gated ion channel VDAC3; Outer mitochondrial membrane protein porin 3; rVDAC3; VDAC protein; VDAC-3; voltage-dependent anion-selective channel protein 3
基因别名: HD-VDAC3; VDAC-3; VDAC3
UniProt ID: (Human) Q9Y277, (Mouse) Q60931, (Rat) Q9R1Z0
Entrez Gene ID: (Human) 7419, (Mouse) 22335, (Rat) 83532